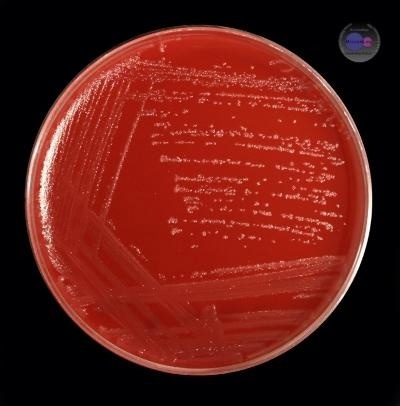
Культура возбудителя столбняка на КМПА Культура возбудителя столбняка на КМПА

Автор и зам. руководителя сообщества Биореактор: врач-онколог Артемий Липилин

Не соответсвует тематике хабра!

Просим всех людей, кто считает, что Хабр только для для тех кто пишет статьи о программах, как например человек на скриншоте, ознакомьтесь, пожалуйста, с мнением администрации на этот счёт в комментариях под нашей статьёй о слепнях. Если Вас это не удовлетворит, то, пожалуйста, не тратьте своё время на прочтение данной статьи!
Эта статья абсолютно соответствует тематике тех хабов, в которых эта статья находится и той сложности технического материала, которую требуют от статьи данные хабы. Лучше переходите сразу к прочтению других материалов, которые соответствуют вашим потребительским предпочтениям. Открою вам истину капитана: лента Хабра настраивается так, как захотите вы! Не нравятся наши статьи, читайте хабы, где пишут исключительно по IT! Не портите себе настроения, уважайте мнение других и хорошего Вам дня! Живите дружно!

Впервые описание болезни, похожей на столбняк, можно встретить в хирургическом папирусе Эдвина Смита, относящемся, приблизительно к 1500 году до нашей эры. Упоминание о столбняке обнаружено также в папирусе, найденном в пирамиде Хеопса и датированном 2600 годом до нашей эры [17]. Однако впервые клиника столбняка достаточно чётко описана «отцом медицины» Гиппократом в IV–III веках до нашей эры. Он же дал название этой болезни. Вот какую запись можно встретить в его знаменитом «Гиппократовом сборнике»:

«Капитан большого корабля ударил указательный палец правой руки якорем. Семь дней спустя из раны появилось отвратительное выделение, а потом обнаружились проблемы с языком: он пожаловался, что не может говорить должным образом. Было диагностировано присутствие тетануса: челюсти сжались, зубы были сомкнуты. Затем появились симптомы в шее, на третий день развился опситонус с потоотделением. Через шесть дней после установления диагноза он умер»*.[3]
Не менее интересно, красочно и полно в I веке н.э. описал столбняк древнеримский врач Аретей из Каппадокии:

«Столбняк во всех его разновидностях – это спазм, чрезвычайно болезненный и очень быстрый, чтобы оказаться смертельным. Существует три формы конвульсий, а именно по прямой линии, с выгибанием назад и вперёд. А есть напряжение по прямой линии всего тела, изогнута и негибка, что называется опистонусом. Он изгибает пациента назад, как лук, так что отогнутая голова оказывается между лопатками; горло торчит; рот открывается, иногда видно сомкнутые зияющие челюсти; дыхание тяжёлое; живот и грудь впуклые…; брюхо вытянуто и резонирует, если постучать по нему; руки сильно согнуты…».[10]
Аретей отмечал, что к числу этиологических моментов столбняка относятся роды и аборты. Однако главным условием, вызывающим столбняк, он считал войны и связанные с ними ранения.
Не менее яркие описания этой болезни можно встретить у других античных и средневековых авторов: Галена, Цельса, Аурелиануса, Авиценны и Абруаза Паре. Последний с уверенностью определял это заболевание как тяжёлое осложнение различных ран.
Во время больших войн, особенно при длительной окопной войне в осеннее время, столбняк принимал эпидемический характер. Американская война за независимость, Французская революция, Наполеоновские войны дали много материала по изучению столбняка. [2]


Инфекционный характер столбняка доказывался рядом авторов со времён Франко-прусской войны. В числе учёных, высказывавших такие предположения, был великий русский хирург Н.И. Пирогов.[5]

Но подлинно научное изучение сути столбняка началось лишь с середины 80-х годов XIX века – в «Золотой век» бактериологии. В 1883 году русский хирург Н.Д. Монастырский при исследовании отделяемого тканей большого пальца человека, погибшего от столбняка, обнаружил новый палочковидный организм и высказал предположение о выделении этой бактерией стрихниноподобного алкалоида.[5] Годом позже молодой немецкий учёный Николайер обнаружил аналогичный микроорганизм после введения земли под кожу кроликам и морским свинкам.
В том же году итальянские учёные Карле и Раттоне смогли вызвать у кроликов типичный столбняк путём введения им в мышцы, спинномозговой канал и оболочку седалищного нерва эмульсии из раны человека, умершего от столбняка. В 1886 году Розенбах обнаружил в гное из раны ноги больного столбняком человека бактериальные формы микроорганизма со спорами, аналогичные выделенным Николайером.[5]

В 1887 году чистую культуру возбудителя открыл Китасото, а в 1890 году он же получил свободный от микроорганизма токсин. В том же году он и Беринг, экспериментируя сначала с кроликами, а потом с лошадьми, создали антитоксическую сыворотку и предложили её в качестве лечебного средства. В 1923–1926 годах французский исследователь Рамон после длительного воздействия формалином при температуре 39–40ﹾС на столбнячный токсин получил анатоксин (вещество получаемое путём химической или физической обработки токсина, не обладающее токсическими свойствами, но способное вызывать выраженный иммунный ответ), который в последующем стали использовать в качестве предохранительного средства от этой болезни.[15] Возбудитель столбняка – грамположительные палочки с закруглёнными концами длиной 4–8 мкм и толщиной 0,3–0,8 мкм.

Они подвижны, содержат двадцать и более жгутиков, расположенных по периферии клетки. В мазках располагаются одиночно или цепочками.[9] Палочка столбняка образует круглые, реже овальные споры, расположенные терминально (на концах). Диаметр спор в два-три раза превышает толщину бактерии, вследствие чего они напоминают теннисные ракетки или барабанные палочки. Споры устойчивы к химическим и физическим воздействиям. Они выживают в течение 8–10 часов в однопроцентном растворе сулемы и пятипроцентном растворе фенола, а также выдерживают кипячение в течение 0,5–1 часа. Однопроцентный раствор формалина вызывает гибель спор в срок от нескольких минут до шести часов. Раствор формалина 0,3% обнаруживает непостоянное бактерицидное действие. Споры в нём живут от нескольких дней до нескольких месяцев.
Бактерицидное действие формалина зависит также и от количества спор в среде: чем больше спор, тем слабее его действие. Споры различных штаммов обладают неодинаковой устойчивостью по отношению к формалину.[15]

Во влажной среде споры выдерживают нагревание до 80ﹾС шесть часов, а до 90ﹾС – два часа. При кипячении они погибают через 30–50 минут. В сухом состоянии споры переносят ещё более высокие температуры: нагревание до 115ﹾС разрушает их только через двадцать минут. Под действием рассеянного солнечного света споры погибают через значительное время. Будучи защищёнными от солнечного света в почве и на различных предметах (колючки растения, гвозди, щепки, сельскохозяйственные орудия), споры могут сохраняться в течение многих лет. На загрязнённой коже они также могут сохранять свою жизнеспособность значительное время.[15]

В 1930 году Мюррей посеял 34 штамма столбнячной палочки на среду из настоя сердца и с 1,8% агара. Через 29 лет споры в посевах дали типичный рост при пересеве на новую среду. [15]
Возбудитель столбняка – строгий анаэроб. Он отличается высокой чувствительностью к кислороду. На простых питательных средах возбудитель растёт медленно и образует тонкие прозрачные колонии двух типов: гладкие, прозрачные S-колонии и серовато-жёлтые, шероховатые R-колонии. S-колонии создают отростки, придающие им паукообразную форму. Позднее отростки сливаются, образуя на поверхности среды «сеточку».
При посеве столбиком на полужидкую питательную среду через 24–48 часов S-колонии приобретают вид пушинок с плотным коричневым центром, а R-колонии – вид чечевицы.[9] При симбиозе с некоторыми микробами палочка столбняка может быть выращена и в аэробных условиях. Наиболее способствуют росту палочки микробы, жадно поглощающие кислород, например, сенная палочка. Далее росту столбнячной палочки способствует параллельный рост стафилококка, протея или синегнойной палочки.[15] В анаэробных условиях, при температуре 37ﹾС, достаточной влажности и в присутствии аэробных бактерий (например, стафилококков) споры прорастают в вегетативные формы.[9]
В организм человека возбудитель проникает в виде спор через повреждённые кожные покровы и слизистые оболочки. При анаэробных условиях в глубоких колотых ранах, ранах с глубокими карманами или некротизацией происходит развитие и размножение вегетативных форм, сопровождающееся выделением экзотоксина.[8]
За пределы раневой поверхности и регионарных лимфатических узлов возбудитель столбняка не распространяется. Так, Розенбергу при исследовании больных столбняком, несмотря на большой материал (свыше шестисот случаев), ни разу не удалось получить культуру столбняка из крови больных.[12]

В ходе своей жизнедеятельности возбудитель столбняка выделяет экзотоксин, который является вторым по токсичности веществом на Земле. В 30–40-х годах ХХ века исследователи печально знаменитого японского отряда 731 пытались приспособить возбудителя столбняка под биологическое оружие. К счастью, в ходе исследований выяснилось, что токсин неустойчив во внешней среде и разрушается от тепла, выделяющегося при взрыве боеприпаса, а осколочные раны, причиняемые боеприпасом, начинённым возбудителем столбняка, не отличаются по степени опасности от обычных осколочных ран.
Столбнячный экзотоксин состоит из трёх фракций: тетанолизина, тетаноспазмина и протеина, усиливающего синтез ацетилхолина.[11] Тетанолизин обладает гемолитическим действием, патогенетически (патогенез — механизм возникновения и развития заболевания) менее значим, проявляет гемолитическое (разрушает эритроциты), кардиотоксическое и летальное действие.

Максимальное накопление токсина в культуре наблюдается уже через 20–30 часов, а процессы его образования не связаны с синтезом тетаноспазмина. [11]Тетаноспазмин, протеин вызывающий спастическое (непроизвольное сокращение мышц) действие, а поскольку бактерии не покидают первичного очага инфицирования, заболевание, по сути, представляет собой преимущественно интоксикационный процесс – токсемию.[11] Большая проблема в том, что тетаноспазмин, в отличие от самого возбудителя, не остаётся только в месте проникновения микроорганизма.
Продуцируемый вегетативными формами возбудителя в анаэробных условиях токсин поступает из ран по двигательным волокнам периферических нервов и через кровь в спинной и продолговатый
Основным путём поступления токсина в спинной
Токсин путешествует по нервным волокнам и поднимается к спинному и головному

Передачу нервного импульса между двумя нервными клетками, или нейроном и мышечным волокном, обеспечивает специальная молекула – нейромедиатор, а самое место соединения называется синапсом. Чтобы нейромедиатор поступил в синаптическую щель, вокруг него нужно сформировать мембранный пузырёк – везикулу. При помощи специальных белков-помощников везикула должна прикрепиться к мембране клетки изнутри, затем слиться с ней, чтобы вещество оказалось снаружи и «поплыло» к принимающей стороне – рецепторам на мембране постсинаптической клетки.
Нейромедиаторы бывают возбуждающими и тормозными. Чтобы все нейрональные цепи работали слаженно, в них должен поддерживаться баланс возбуждения и торможения. Тетаноспазмин прицельно разрушает
белки тормозного нейромедиатора – гамма-аминомасляной кислоты (ГАМК). Такими белками-помощниками являются два синаптических белка: синаптобревин и целлюбревин. Разрушая их, токсин подавляет высвобождение ГАМК.[13]
Постоянное, дискоординированное поступление двигательных импульсов от мотонейронов к мышцам сопровождается гиперпродукцией и гиперсекрецией ацетилхолина в нервно-мышечных синапсах (за это отвечает третий компонент экзотоксина – протеин, стимулирующий синтез ацетилхолина) и приводит к постоянному тоническому напряжению скелетной мускулатуры. Поскольку токсин оказал своё негативное действие в ретикулярной формации, то теперь все «составы» нервных импульсов от чувствительных рецепторов на огромной скорости проносятся через «сортировку» прямо в кору больших полушарий. Это приводит к формированию там очагов патологического возбуждения. В результате, в ответ на тактильные, слуховые, зрительные, обонятельные, вкусовые и прочие раздражители возникают клонико-тонические и тетанические судороги.
Необходимо отметить, что в первую очередь происходит сокращение поперечнополосатых мышц, ближайших к месту травмы и выступающих в качестве «самых сильных» в организме человека.[16]
Помимо этого, блокада нейронов ретикулярной формации ствола
В результате постоянного мышечного напряжения, в мышцах накапливается молочная кислота и развиваются нарушения микроциркуляции. Это приводит к повышению рН – ацидозу. Возникает порочный круг: метаболический ацидоз и нарушения микроциркуляции ведут к развитию судорог, а судорожный синдром, в свою очередь, усугубляет метаболический ацидоз и нарушение микроциркуляции. Если больной не умирает на пике судорожного приступа от остановки дыхания или сердечной деятельности, то при дальнейшем течении болезни причинами смерти могут быть прямое действие токсина на дыхательный и сосудодвигательный центры в сочетании с глубокими метаболическими нарушениями или гнойно-септические осложнения. Не исключается, однако, и непосредственное действие тетаноспазмина на электролитный транспорт.[8]
На аутопсии у погибших от столбняка характерные изменения не отмечаются. Наблюдаются выраженное полнокровие внутренних органов и множественные мелкие кровоизлияния в слизистые и серозные оболочки.[1]
И тем не менее, при вскрытии умерших от столбняка пациентов есть некоторые особенности, которые можно обнаружить как при осмотре, так и при микроскопическом исследовании. Определение спороносных возбудителей столбняка на месте их фиксации в ране представляет трудности, так как они могут локализоваться лишь в одном её ограниченном участке, благодаря чему необходимы многократные мазки из разных отделов. В некоторых случаях возбудителя можно обнаружить в гистологических срезах, например, в области пупочной ямки при столбняке новорожденных.[12]
При осмотре тела человека, погибшего от столбняка, обращает на себя внимание то, что температура трупа может не соответствовать срокам посмертного охлаждения и даже подниматься до 42ﹾС и выше. Это объясняется усиленной теплопродукцией мышц при судорогах, причём распространение тепла от мышц к поверхности тела происходит довольно медленно, поэтому повышение температуры может наблюдаться даже после смерти. При раннем вскрытии умерших от столбняка обращает на себя внимание выраженное трупное окоченение сгибательной и разгибательной мускулатуры в соответствии с прижизненным сокращением мышц-антагонистов. Предполагается, что раннее наступление окоченения связано с резким накоплением молочной кислоты в мышцах вследствие их функционального перенапряжения. Иногда макроскопически определяются участки коагуляционного (сухого) некроза мышц, подвергшихся наибольшему функциональному напряжению, особенно в местах перегибов через неподатливые части скелета, например, в пояснично-подвздошных мышцах при пересечении ими тазовых костей. Развитие фокусов таких некрозов также связано с судорожным сокращением мышц и их аноксическим (бескислородным) состоянием. В области некрозов особенно легко наступают разрывы отдельных групп волокон с последующими кровоизлияниями в местах разрывов, а иногда и с крупными гематомами. Кровоизлияния в мышцах в результате повреждений сосудов при чрезмерных судорожных сокращениях могут быть и без определимых участков некрозов или разрывов. Кроме того, они могут возникнуть путем пропитывания форменных элементов крови через стенку сосуда при длительной гипоксии тканей.[15]
Описанные патологоанатомические изменения выделяют столбняк из ряда других инфекций как своеобразную форму интоксикаций, при которой не обнаруживается никаких постоянных или специфических изменений во внутренних органах или в нервной системе.[20]
Источником инфекции являются преимущественно травоядные животные (овцы, коровы, лошади и др.), а также собаки, кошки, крысы, куры и человек. В их кишечниках обитают вегетативные формы возбудителя столбняка, продуцирующие экзотоксин, не проникающий через неповреждённую слизистую оболочку кишечника. [20] Существует гипотеза, согласно которой разная восприимчивость людей к столбняку связана с тем, что организмы, в кишечнике которых встречается возбудитель столбняка, постоянно «иммунизируются» микродозами токсина, формируя активный иммунитет.
Возбудитель столбняка с кишечным содержимым животных выделяется во внешнюю среду, где споры бацилл могут сохраняться длительное время. Палочки столбняка не размножаются в почве, но их споры, попадая в кишечники человека и животных, превращаются в вегетативные формы, размножаются и с испражнениями снова в огромных количествах возвращаются в почву, сохраняясь там до тридцати лет.[6]
По данным ВОЗ, в мире ежегодно погибает от столбняка около пятидесяти тысяч человек, причём специалисты полагают, что истинное число умерших в несколько раз выше. В странах Африки столбняк является одной из основных причин госпитализации взрослого населения.[8]
Уровень ежегодной заболеваемости существенно зависит от соотношения вакцинированных и непривитых лиц и от проведения экстренной профилактики, достигая в развивающихся странах 10–50 случаев на 100000 населения. В развитых странах, где массовая вакцинация начата с 1950-х годов, заболеваемость почти на два порядка ниже. [4]
Дети, составляющие 40–55% всех заболевших, заражаются обычно при бытовых и уличных травмах. Столбняк у них возникает чаще в возрасте 3–7 лет, в период быстрого развития моторики.[19]
В развивающихся странах более 10% всех случаев столбняка, полученного в результате инфицирования пупочной раны, приходится на новорождённых. Так, в некоторых южных областях распространён столбняк новорожденных что связано с обычаем засыпать пуповину высушенной землёй. Всего на долю новорожденных приходится 80% случаев заболевания столбняком.[6]
Во время войн и стихийных бедствий столбняк приобретает значение настоящего травматического эпидемического заболевания, особенно в условиях окопной позиционной войны, поскольку такая война обуславливает длительное пребывание масс в окопной обстановке, когда тела и одежда людей загрязняются пропитанной нечистотами почвой. [16]
Инкубационный период длится от двух до двадцати одного дня, чаще всего три – пять дней. Его продолжительность зависит от формы (вегетативная или споровая), количества микробов, попавших в рану, их токсичности, а также локализации и характера травмы, наличия некротических изменений в ране и состояния иммунитета у травмированного человека.[]
Клинически выраженная картина столбняка длится при благоприятном исходе 2–4 недели, но с 10–15 дня болезни тетанические судороги становятся более редкими и менее интенсивными, а с 17–18 дня они обычно прекращаются полностью, и с этого времени можно говорить о начале периода выздоровления. Тоническое напряжение мышц сохраняется 22–25 дней преимущественно в мышцах спины, живота и в икроножных мышцах. Ригидность распространяется как бы в нисходящем порядке: шея, спина, живот и конечности.[12]
При распространении мышечного тонуса на мимические мышцы черты лица искажаются, на лбу и вокруг глаз появляются морщинки, рот растягивается, его углы опускаются или приподнимаются, придавая лицу своеобразное выражение одновременного плача и иронической улыбки («сардоническая улыбка» – risus sardonicus).[15]

В течение двух – четырёх суток повышается тонус мышц затылка, спины, живота, проксимальных отделов конечностей, особенно нижних. Гипертонус распространяется по нисходящему типу. [1] Вследствие судорог тело может приобретать разнообразные, иногда причудливые положения (tetans acrobaticus). Наиболее часто наблюдается запрокидывание головы с дугообразным выгибанием позвоночника, когда тело больного опирается на затылок и пятки (опистотонус). Однако не стоит думать, что опистотонус является единственно возможным вариантом течения столбняка. При преобладании судорожного сокращения всех сгибательных мышц туловища вместо опистотонуса больной принимает положение эмпростотонуса (сгорбленная спина, опущенная на грудь голова), при равномерном сокращении всех мышц тела – положение ортотонуса (прямое положение), и, наконец, при преобладании сокращения мышц одной стороны – положение плевростотонуса (боковое положение).[4]
Тоническое напряжение захватывает межрёберные мышцы, диафрагму и голосовую щель, вследствие чего уменьшается минутный объём дыхания, возникают гипоксия (снижение концентрации кислорода в крови) и гиперкапния (повышение концентрации в крови углекислого газа).

.Особенностями поражения мышечной системы при столбняке служат вовлечение в процесс только крупных мышц конечностей, их постоянный гипертонус и ярко выраженные боли. В разгаре болезни на этом фоне под влиянием любых, даже незначительных по силе раздражителей, возникают общие тетанические судороги продолжительностью от нескольких секунд по одной минуты.[8]
Сила сокращения мышц в период судорог настолько велика, что может привести к переломам тел позвонков, отрыву мышц от мест прикрепления, разрывам мышц передней брюшной стенки и конечностей. Иногда развиваются компрессионные деформации позвоночника.[2]
При появлении клинических симптомов болезни токсин в крови невозможно обнаружить даже самыми чувствительными методами. Выявление антитоксических антител не имеет диагностического значения, поскольку оно свидетельствует лишь о прививках в анамнезе. При столбняке нарастание титров антител не происходит, так как даже летальные дозы экзотоксина не вызывают иммунного ответа.[14]
С целью установления диагноза проводится биопроба: патологический материал, полученный от пациента, вводится подкожно или внутримышечно белым мышам. При наличии в исследуемом материале возбудителя столбняка или тетаноспазмина через одни – двое суток у мышей появляется характерный признак болезни – несгибаемый хвост. Затем начинаются общие судороги, и животное погибает.[15]
Столбняк относится к особому типу инфекционных болезней, при которых на первое место в лечении выходит не применение антибактериальных препаратов, а терапия, направленная на устранение жизнеугрожающих и мучительных для пациента симптомов. Центральное место в интенсивной терапии столбняка занимает уменьшение или полное снятие тонических и тетанических судорог. Так, в настоящее время при лечении столбняка пациента погружают в управляемую медикаментозную кому. С помощью миорелаксантов снимают напряжение мускулатуры. К сожалению, при применении таких препаратов расслабляется и дыхательная мускулатура, что требует подключения пациента к аппарату ИВЛ. Поскольку человек в сознании не может находиться на ИВЛ, пациента, что называется, «седируют» – вводят в состояние медикаментозного сна. Это позволяет избежать сопротивления пациента аппарату ИВЛ и снять очаги патологического возбуждения в ЦНС.[8]
Наряду с этим пациенту вводят антитоксическую сыворотку, однако следует помнить, что только не связанный токсин может быть нейтрализован антитоксическими антителами. Так что, если тетаноспазмин попал в организм и связался с клетками ЦНС, можно только ждать, пока он будет разрушен и выведен из организма.[8]
К счастью, столбняк относится к группе так называемых управляемых инфекций, то есть его можно контролировать путем профилактической вакцинации. Начиная с 60-х годов ХХ века, столбнячный анатоксин находится в составе разных вакцин, входящих в календарь профилактических прививок, что позволяет свести к минимуму риск заражения этой «замечательной» болезнью. Поэтому советую не забывать своевременно «обновлять свои вирусные базы».
До новых встреч!

* Здесь и далее курсив мой. В цитатах сохранены орфография и пунктуация авторов. – А.Л.
Список использованной литературы
Основная
-
Билибин А.Ф. Бунин К.В, Курс инфекционных болезней. – М.: Медгиз, 1956.
-
Большая медицинская энциклопедия. Том XXXI/ Под ред. А.Н. Бакулева. – М.: Советская энциклопедия,1961.
-
Гиппократ. Сочинения в 3-х томах. /Пер. с греческого [В.И. Руднев] Т. I – II. – М: Книга по требованию. Репринт издания, 1936.
-
Данилевич М.Г. Острые детские инфекции. – Л.: Медгиз, 1960.
-
Ивашенцов Г.А., Тушнский М.Д., Башенин В.А., Данилевич М.Г. Курс острых инфекционных болезней. –М.: Медгиз,1951.
-
Инфекционные болезни жарких стран. /Под ред. А.А. Сохина. – Киев: Висша школа,1982.
-
Инфекционные и паразитные болезни развивающихся стран/ Под ред. Чебышева Н.В., Пака С.Г. – М.: ГЭОТАР-Медиа, 2008.
-
Инфекционные болезни. Национальное руководство. /Под ред. Н.Д. Ющук Ю.Я. Венгеров. – М.: ГЭОТАР-Медиа, 2009.
-
Медицинская микробиология./ Под ред. В.И. Покровского. Изд. 3-е. – М.: Издательская группа ГЭОТАР-Медиа, 2005.
-
Паевский А.С. Вот холера! – М.: АСТ, 2020.
-
Покровский В.И., Пак С.Г., Брико Н.И. Данилкин Б.К. Инфекционные болезни и эпидемиология. – Изд. 2-е. – М: Издательская группа ГЭОТАР-Медиа, 2004.
-
Розенберг Н.К. Инфекционные болезни. Л.: Медгиз,1938.
-
Руководство по инфекционным болезням./ Под ред. Лобзина Ю.В. –Изд. 3-е. – СПб.: Фолиант,2003.
-
Руководство по инфекционным болезням./Под ред. Покровского В.И., Лобана К.М. – Изд. 2-е М.: Медицина,1986.
-
Руководство по микробиологии, клинике и эпидемиологии инфекционных болезней. Том VII. /Под ред. К.И. Матвеева, П.А. Петрищева. – М.: Медицина,1966.
-
Сорокина Т.С. «История медицины» издание 8-е Издательский центр «Академия» М.: 2008
-
Справочник по инфекционным болезням./ Под ред. гл. эпидемиолога Красной армии И.Д. Ионина. – Изд. 2-е. – М.: Медгиз,1944.
-
Справочник по инфекционным болезням у детей./Под ред. Тришковой Л.А., Богатырёвой С.А. – Киев:Здоровья,1990.
-
Учайкин В.Ф., Нисевич Н.И., Шамшева О.В. Инфекционные болезни у детей. – М.: ГЭОТАР-Медиа, 2010.
-
Шувалова Е.П. Инфекционные болезни. – М.: Медицина, 2005.
Дополнительная
-
Абу Али ибн Сино Канон врачебной науки. Том IV. издание 3-е. Ташкент.: издательство медицинской литературы им. Абу Али ибн Сино,1996.
-
Громашевский Л.В. Вайндрах Г.М. Частная эпидемиология. – М.: Медгиз, 1947.
-
Кузьмичева А.Т, Шарлай И.В. Детские инфекционные болезни. – М.: Медицина,1984.
-
Медуницын Н.В. Вакцинология. – М.: Триада-Х,1999.
-
Носов С.Д. Детские инфекционные болезни. – М.: Медицина,1982.
-
Основы патологии заболеваний по Роббинсону и Котрану. Т 3. – М.: Логосфера, 2016.
-
Пяткин К.Д. Микробиология. – М.: Медицина, 1963.
-
Руководство по педиатрии.Том 6. / Под ред. М.М. Бубнова. – М.: Медицина,1964.
-
Фанкони Г., Вальгрен Л. Руководство по детским болезням.– М.: Медгиз,1960.
Автор: Биореактор
